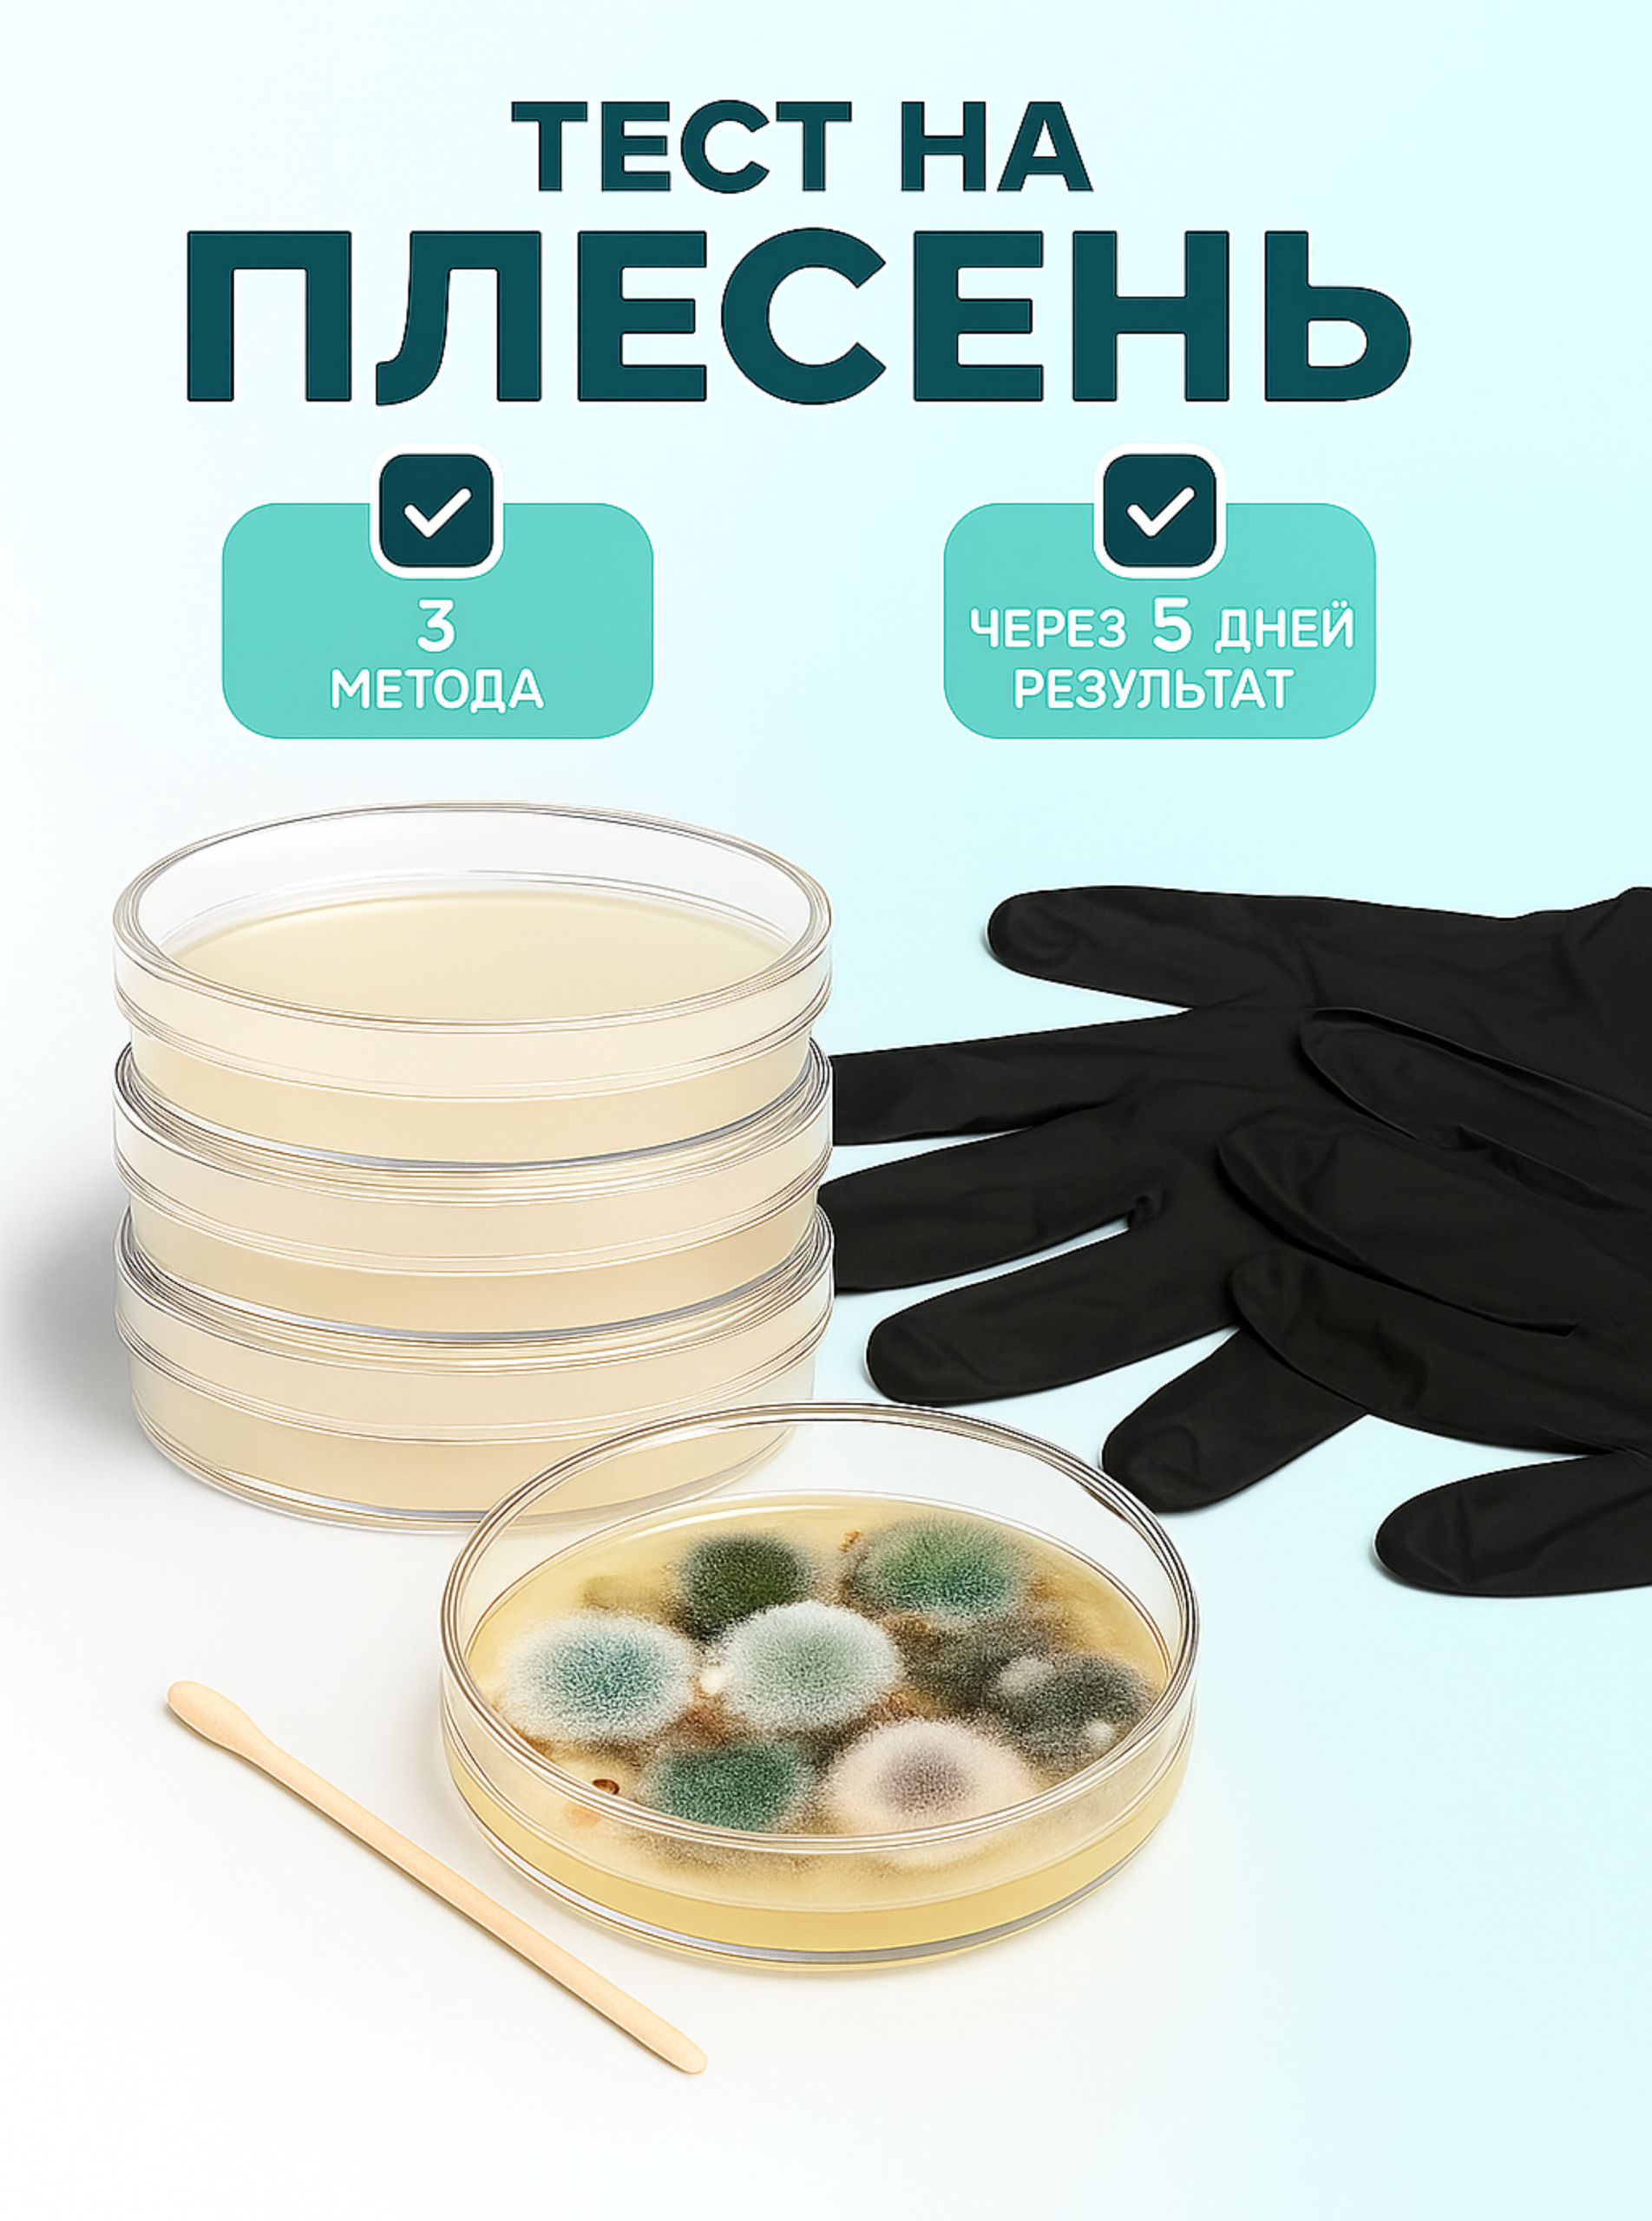

Тест на плесень PDA — это уникальный инструмент для обнаружения плесени в воздухе и доме. Он позволяет быстро и точно определить наличие плесени, что особенно важно при ремонте или переезде в новый дом. Этот тест поможет вам избежать проблем со здоровьем, связанных с плесенью, и обеспечит комфортную жизнь в вашем новом жилье.

Отзывы
Отзывов пока нет.